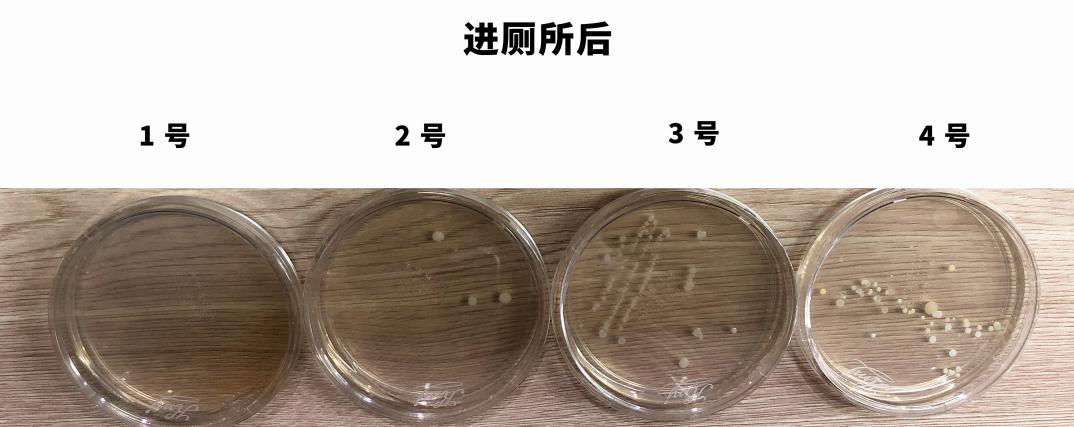
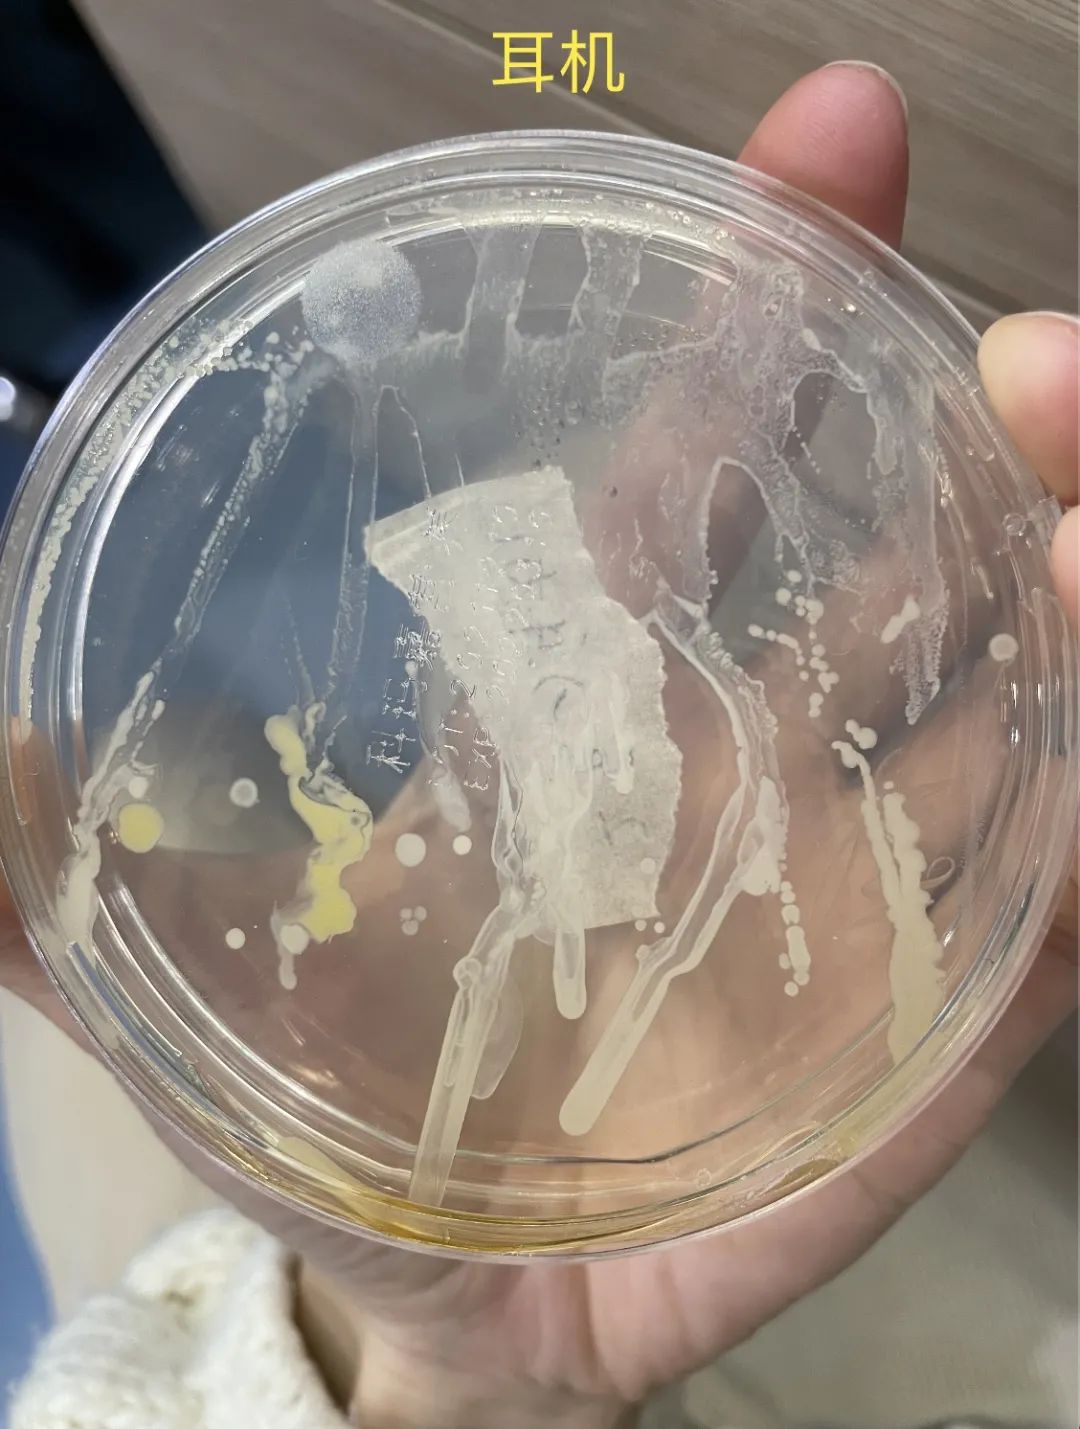

- +1
真心劝你,上厕所千万不要带手机
原创 Murphy 丁香医生
 如果有一天你跟我们一样,站在厕所门口半小时,你就会发现很多有趣的事。
如果有一天你跟我们一样,站在厕所门口半小时,你就会发现很多有趣的事。比如这样:
 这样的:
这样的: 还有这样的:
还有这样的: 他们都有一个共同特点:带手机进厕所!
他们都有一个共同特点:带手机进厕所!怎么就把手机带进厕所了!手机才是厕所的标配吗!?
「手机带进厕所」的田野调查
到底有多少人会把手机带进厕所呢?我们认真做了一个调查。
地点:某办公楼
时间:2022 年 1 月 18 日 15:00~16:00
调查方式:肉眼数数+记录
 结果,我们发现:
结果,我们发现:进厕所的人数 34 人,其中带手机的高达 91.1%(也就是 31 人)!
我们友好地随机采访了带手机进厕所的同事:
 老板快看这里
老板快看这里 当然也有一些意外的,我们还采访到了其中一个没带手机的人,得到的回答竟然是:
 不禁让人发出这样一句呐喊:
不禁让人发出这样一句呐喊:你们就不怕从厕所带出点啥吗?
 图片来源:giphy.com
图片来源:giphy.com带进厕所的手机会带出什么东西?
为了进一步搞清楚这个问题,我们弄来了二十个细菌培养皿,决定做一个小实验!
已经放假流量充足的朋友可以点击以下视频看完整的实验过程,还在上班摸鱼努力工作的朋友可以继续阅读以下文字版本。
简单来说,就是在进入厕所前制造相对无菌的状态(包括手和手机),等从厕所出来之后,对手机进行(细菌培养)检测确定「带出来了什么」。
严谨起见,我们在专家的指导下,完成了我们的整场实验。
1消毒
2进前
取样
3 进后
取样
4 培养
参与者:蹲在厕所门口随机抽取 4 人(2 男 2 女)
实验过程:
➊ 实验人员在厕所门口发放无菌手套,并对参与者的手机进行消毒;
➋ 消毒完成后用棉签棒沾取手机正反面,取样后在培养基上划涂;
➌ 等待参与者上完厕所出来,收取参与者上完厕所后的手机,并用棉签棒沾取手机正反面,取样后在培养基上划涂;
➍ 取样后放进酸奶机 72 小时(制造恒温环境 35 度左右)。
72 小时后……
我们发现:基本消毒完手机都是比较干净,当然也有意外的时候(4 号长出 1 个小菌落)。
总体而言还是比较干净的!
 进厕所之后的现象,就大不相同了!3、4 号都带出来了不少细菌。
进厕所之后的现象,就大不相同了!3、4 号都带出来了不少细菌。 按参与者的交代,他们蹲坑的时候一直在玩手机,而且 4 号还放到了台子上。
按参与者的交代,他们蹲坑的时候一直在玩手机,而且 4 号还放到了台子上。其中神奇的 1 号几乎都没有微生物!
她事后说她进去就揣兜里了,而且进去都是用纸巾碰把手,看来这还真是一个保护手机的好方法啊。(不过,那为什么要带手机进去呢?)
为了避免苛刻的同事说不严谨,我们还特别考虑到了一个问题:
会不会是整个办公大楼的空气就不干净,落到手机上了?
我们增加做了空白组,以证明手机上的细菌真的就是厕所里带出来的。
空白组培养皿:1 台手机放在座位上测办公室环境,消毒完取样,并在静置 5 分钟后取样,都放进酸奶机 72 小时。
等等!意外发生了,在座位上的两台手机居然出现了显著的差异。
 放在座位上的手机 5 分钟后同样长出了菌!
放在座位上的手机 5 分钟后同样长出了菌!难道厕所更少微生物?难道是工位上的这个加湿器?难道是谁在这个期间做了 poop 的事?
 直到 1 号参与者终于勇敢地站了出来!
直到 1 号参与者终于勇敢地站了出来! 原来是这个同事上完厕所(实验)回来(带着手套)之后又玩了一会手机。
原来是这个同事上完厕所(实验)回来(带着手套)之后又玩了一会手机。也就是说:这些玩意儿来自于手?!
带着最多脏东西的
可能是你的手!
可是这也不能随便说说,为了搞清楚我们从厕所带出更多东西的是手,还是手机,我们把目光投向了那堆没用完的培养皿上...
先将手机消毒,让两位参与者带无菌手套去厕所玩手机,然后给手套、手机取样。我们还将一台手机还原当时的场景,静置在办公桌上 5 分钟。
当然!这次我们绝对不允许再有意外发生!
我们再乖乖静置 72 小时等待。
于是,我们得到了这样的画面:
 (右边菌落数量和种类多于左边)
(右边菌落数量和种类多于左边)手还真就是那个带东西出来最多的家伙!无论哪一个实验者,手套上的细菌都比手机要更多一些。
想想也非常合理,手会碰到门把手、马桶按钮、还可能会在擦屁股时带到一点……
并且假如你忘了洗手或者是洗手不认真,手还会把细菌带到你的键盘上、你的手机上,你身边的各个角落。
 当然,这并不是一个完全严谨的实验。
当然,这并不是一个完全严谨的实验。我们没有在无菌环境真正保证实验的准确。另外,我们也想一直强调我们活在有很多微生物的环境中,有细菌不代表就是有害的。
但厕所,的确是我们需要警惕的地方。
不少文献已经发现,厕所能带出的不仅有粪便中常带的大肠杆菌、还有对人体有害的金黄色葡萄球菌等等。
一个有趣的数据:一克人类粪便——可能含有一万亿个细菌。
我们(研究经费有限只能)查阅了文献发现,上厕所前后人的手上都会带着大肠杆菌,而上完厕所没洗手的话,手上检测出大肠杆菌的人数陡增 6 倍,将近 1/4 的人手上检测出了这种菌。
特别是想象一下,去到环境更为复杂的公共厕所之类的,从厕所里能带出来多少脏东西。
 所以我们劝你,能不带就不带吧,毕竟对痔疮也有好处,上个厕所 3~5 分钟就够了。
所以我们劝你,能不带就不带吧,毕竟对痔疮也有好处,上个厕所 3~5 分钟就够了。如果实在戒不掉(带薪拉屎)上厕所带手机的习惯,那至少千万一定:
上完厕所洗手呀!
洗够 20 秒!
(也就是唱两遍生日快乐的时间)
还没结束,别走!
难得做回实验我们还有很多料
彩蛋一
一小时观察 34 人中居然只有 10 个人洗够了 20 秒,也就是 70% 的人根本没洗干净手啊!
而且其中有 2 个人连手都没洗(科普还不够到位啊)小心!我们看着你呢!说的就是你!
彩蛋二
马桶按键上真的很多「小生物」
 好奇点击|高能预警
好奇点击|高能预警彩蛋三
还有一些意想不到的细菌培养,比如没消过毒的耳机:
好奇点击|高能预警
好奇点击|高能预警赶紧转给你那个爱带手机上厕所还不好好洗手的朋友吧!
本文审核专家
 韩 越
韩 越剑桥大学病毒助理研究员
参考文献
[1] Faecal micro-organisms on the hands of carriers: Escherichia coli as model for Salmonella [1992]
Wit, J.C. de (Agricultural Univ., Wageningen (Netherlands). Dept.of Food Science); Rombouts, F.M.;
[2] https://www.bankmycell.com/blog/cell-phone-usage-in-toilet-survey#jump10
[3] Rico E, Pérez C, Belver A, et al. Norovirus detection in environmental samples in norovirus outbreaks in closed and semi-closed settings[J]. Journal of Hospital Infection, 2020, 105(1): 3-9.DOI: 10.1016/j.jhin.2020.02.011
策划制作
策划:Murphy、阿官 | 监制:Feidi
排版:甲鱼 | 插图:自己拍的 & 站酷海洛
封面图来源:自己拍的
本文为澎湃号作者或机构在澎湃新闻上传并发布,仅代表该作者或机构观点,不代表澎湃新闻的观点或立场,澎湃新闻仅提供信息发布平台。申请澎湃号请用电脑访问http://renzheng.thepaper.cn。





- 报料热线: 021-962866
- 报料邮箱: news@thepaper.cn
互联网新闻信息服务许可证:31120170006
增值电信业务经营许可证:沪B2-2017116
© 2014-2026 上海东方报业有限公司




